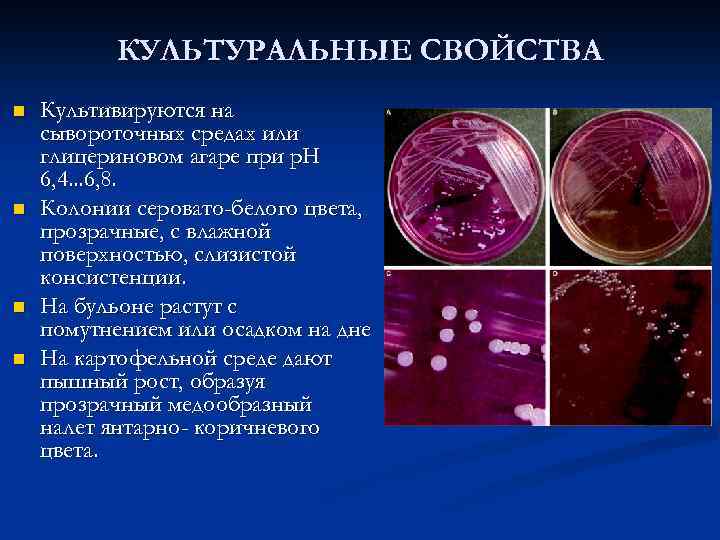
КУЛЬТУРАЛЬНЫЕ СВОЙСТВА n n Культивируются на сывороточных средах или глицериновом агаре при р. Н

762861.ppt
- Количество слайдов: 12
 Сап однокопытных. n Выполнил: Ерденов Шынгыс 12 -701 -13
Сап однокопытных. n Выполнил: Ерденов Шынгыс 12 -701 -13
 САП преимущественно хронически протекающая болезнь однокопытных, характеризующаяся появлением во внутренних органах, на слизистых оболочках и кожных покровах специфических узелков, при распаде которых образуются язвы Фридрих Леффлер 1882
САП преимущественно хронически протекающая болезнь однокопытных, характеризующаяся появлением во внутренних органах, на слизистых оболочках и кожных покровах специфических узелков, при распаде которых образуются язвы Фридрих Леффлер 1882
 ТАКСОНОМИЯ и МОРФОЛОГИЯ СЕМЕЙСТВО Pseudomonadaceae (Burkholderiaceae ) РОД Pseudomonas (Burkholderia ) ВИД mallei n Тонкие прямые или слегка изогнутые палочки n Имеются неподвижные и подвижные штаммы n Встречаются нитевидные формы длиной 8. . . 12 мкм. n Не образуют спор и капсул, n Грамотрицательные n Окраска по Леффлеру, Романовскому-Гимзе
ТАКСОНОМИЯ и МОРФОЛОГИЯ СЕМЕЙСТВО Pseudomonadaceae (Burkholderiaceae ) РОД Pseudomonas (Burkholderia ) ВИД mallei n Тонкие прямые или слегка изогнутые палочки n Имеются неподвижные и подвижные штаммы n Встречаются нитевидные формы длиной 8. . . 12 мкм. n Не образуют спор и капсул, n Грамотрицательные n Окраска по Леффлеру, Романовскому-Гимзе
КУЛЬТУРАЛЬНЫЕ СВОЙСТВА n n Культивируются на сывороточных средах или глицериновом агаре при р. Н 6, 4. . . 6, 8. Колонии серовато-белого цвета, прозрачные, с влажной поверхностью, слизистой консистенции. На бульоне растут с помутнением или осадком на дне На картофельной среде дают пышный рост, образуя прозрачный медообразный налет янтарно- коричневого цвета.
КУЛЬТУРАЛЬНЫЕ СВОЙСТВА n n Культивируются на сывороточных средах или глицериновом агаре при р. Н 6, 4. . . 6, 8. Колонии серовато-белого цвета, прозрачные, с влажной поверхностью, слизистой консистенции. На бульоне растут с помутнением или осадком на дне На картофельной среде дают пышный рост, образуя прозрачный медообразный налет янтарно- коричневого цвета.
 Антигенная структура Существует две разновидности, или антигенные группы, возбудителя сапа: Первая содержит антиген, общий для бактерий сапа и мелиоидоза, Вторая имеет антиген, который содержится только в бактериях сапа. n Из бактерий сапа были выделены две фракции: специфический видовой полисахарид и неспецифический нуклеопротеид. n
Антигенная структура Существует две разновидности, или антигенные группы, возбудителя сапа: Первая содержит антиген, общий для бактерий сапа и мелиоидоза, Вторая имеет антиген, который содержится только в бактериях сапа. n Из бактерий сапа были выделены две фракции: специфический видовой полисахарид и неспецифический нуклеопротеид. n
 ПАТОГЕННОСТЬ Сапом болеют лошади, ослы и мулы. Описаны случаи заболевания сапом хищных зверей: льва, барсука, леопарда, барса, рыси, степной кошки. Болезнь протекает у лошадей в хронической и острой формах; по локализации сап подразделяют на легочный, носовой и кожный. Основной фактор патогенности – эндотоксин, одним из продуктов распада является которого является маллеин, обладающий ярко выраженным аллергическим действием
ПАТОГЕННОСТЬ Сапом болеют лошади, ослы и мулы. Описаны случаи заболевания сапом хищных зверей: льва, барсука, леопарда, барса, рыси, степной кошки. Болезнь протекает у лошадей в хронической и острой формах; по локализации сап подразделяют на легочный, носовой и кожный. Основной фактор патогенности – эндотоксин, одним из продуктов распада является которого является маллеин, обладающий ярко выраженным аллергическим действием
 ПАТОГЕНЕЗ Попадающие в организм через поврежденные покровы или с вдыхаемым воздухом бактерии оседают в мелких капиллярах, где окружаются мононуклеарами и формируют сапные узелки. Под действием фагоцитов и Т-киллеров в центре узелка образуются некротические фокусы. Повышенная порозность стенок мелких сосудов вокруг фокусов приводит к появлению инфильтратов, повышенному проникновению возбудителя влимфо- и кровоток и заносу его в другие паренхиматозные органы и лимфатические узлы. n Вновь формирующиеся фокусы сливаются, образуя каверны. В легких в таких случаях развивается лобулярно-лобарная пневмония. В коже и на слизистых оболочках распадающиеся сапные узелки образуют своеобразные язвы с изрытыми неровными краями и саловидным дном, которые вяло заживают с звездчатым рубцеванием. n Усиливающаяся интоксикация вызывает лихорадку, приводит к истощению и гибели ослабленных животных. n
ПАТОГЕНЕЗ Попадающие в организм через поврежденные покровы или с вдыхаемым воздухом бактерии оседают в мелких капиллярах, где окружаются мононуклеарами и формируют сапные узелки. Под действием фагоцитов и Т-киллеров в центре узелка образуются некротические фокусы. Повышенная порозность стенок мелких сосудов вокруг фокусов приводит к появлению инфильтратов, повышенному проникновению возбудителя влимфо- и кровоток и заносу его в другие паренхиматозные органы и лимфатические узлы. n Вновь формирующиеся фокусы сливаются, образуя каверны. В легких в таких случаях развивается лобулярно-лобарная пневмония. В коже и на слизистых оболочках распадающиеся сапные узелки образуют своеобразные язвы с изрытыми неровными краями и саловидным дном, которые вяло заживают с звездчатым рубцеванием. n Усиливающаяся интоксикация вызывает лихорадку, приводит к истощению и гибели ослабленных животных. n
 КЛИНИКА n n Инкубационный период длится 2. . . 3 нед. Болезнь протекает остро, хронически и бессимптомно (скрыто, латентно). В зависимости от проявления и локализации процесса различают также легочную, носовую и кожную формы сапа. При остром течении сапа отмечают повышение температуры тела, учащение дыхания, покраснение слизистой оболочки носа и одно- или двустороннее слизистое истечение из носовой полости, редкий сухой кашель, потерю аппетита. В дальнейшем на слизистой оболочке носа появляются мелкие желтоватые узелки, окаймленные красным ободком.
КЛИНИКА n n Инкубационный период длится 2. . . 3 нед. Болезнь протекает остро, хронически и бессимптомно (скрыто, латентно). В зависимости от проявления и локализации процесса различают также легочную, носовую и кожную формы сапа. При остром течении сапа отмечают повышение температуры тела, учащение дыхания, покраснение слизистой оболочки носа и одно- или двустороннее слизистое истечение из носовой полости, редкий сухой кашель, потерю аппетита. В дальнейшем на слизистой оболочке носа появляются мелкие желтоватые узелки, окаймленные красным ободком.
 КЛИНИКА n n n Затем узелки распадаются и превращаются в язвы круглой или продолговатой формы с неровными утолщенными краями, покрытые слизисто-гнойным экссудатом, иногда с примесью крови. Выделения из носа кровянисто-ихорозные, дыхание сопящее. Подчелюстные лимфатические узлы припухшие, болезненные, горячие, затем становятся плотными, бугристыми, неподвижными. Иногда в пораженных лимфатических узлах образуются абсцессы. На коже головы, шеи, конечностей, мошонки появляются мелкие узелки, которые затем превращаются в язвы, заполненные гнойно-некротическим содержимым. К концу 2. . . 4 -й недели носовые ходы забиваются кровянисто-гнойными массами, которые выделяются при фырканье и кашле. При остром течении болезнь длится 8. . . 30 дней, животные быстро худеют и гибнут, или сап принимает хроническое течение.
КЛИНИКА n n n Затем узелки распадаются и превращаются в язвы круглой или продолговатой формы с неровными утолщенными краями, покрытые слизисто-гнойным экссудатом, иногда с примесью крови. Выделения из носа кровянисто-ихорозные, дыхание сопящее. Подчелюстные лимфатические узлы припухшие, болезненные, горячие, затем становятся плотными, бугристыми, неподвижными. Иногда в пораженных лимфатических узлах образуются абсцессы. На коже головы, шеи, конечностей, мошонки появляются мелкие узелки, которые затем превращаются в язвы, заполненные гнойно-некротическим содержимым. К концу 2. . . 4 -й недели носовые ходы забиваются кровянисто-гнойными массами, которые выделяются при фырканье и кашле. При остром течении болезнь длится 8. . . 30 дней, животные быстро худеют и гибнут, или сап принимает хроническое течение.
 Хроническое течение сапа n n характеризуется лихорадкой непостоянного типа, исхуданием, слабостью, редким сухим кашлем и эмфиземой легких. Отмечают носовое кровотечение, одностороннее увеличение подчелюстных лимфатических узлов, отеки в области мошонки или вымени. На слизистой оболочке носа обнаруживают звездчатые рубцы или небольшие белые пятна, которые образовались в результате заживления сапных язв. Болезнь длится от нескольких месяцев до нескольких лет.
Хроническое течение сапа n n характеризуется лихорадкой непостоянного типа, исхуданием, слабостью, редким сухим кашлем и эмфиземой легких. Отмечают носовое кровотечение, одностороннее увеличение подчелюстных лимфатических узлов, отеки в области мошонки или вымени. На слизистой оболочке носа обнаруживают звездчатые рубцы или небольшие белые пятна, которые образовались в результате заживления сапных язв. Болезнь длится от нескольких месяцев до нескольких лет.
 БИОПРЕПАРАТЫ n Для лечения и профилактики сапа биопрепараты не разработаны. Сапных животных утилизируют.
БИОПРЕПАРАТЫ n Для лечения и профилактики сапа биопрепараты не разработаны. Сапных животных утилизируют.



